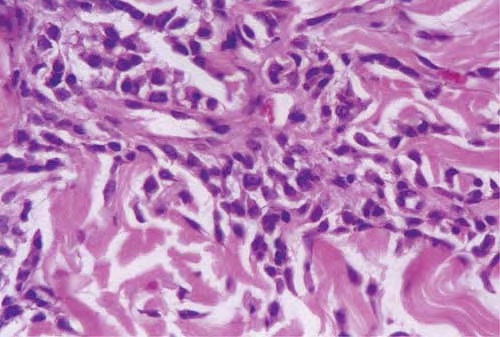

Lentigo maligna melanoma = ميلانوم الشامة الخبيثة
Lentigo maligna melanoma = ميلانوم الشامة الخبيثة Lentigo Maligna Melanoma Lentigo maligna, previously referred to as melanosis circumscripta preblastomatosa of Dubreuilh and also as melanotic freckle of Hutchinson [or Hutchinson’s melanotic freckle (HMF), a term used currently in Australia for this condition], accounts for about 10% of melanomas and typically occurs on the chronically exposed […]
Read More